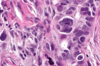

Week 6- ovarian cancer Flashcards
What are the main groups that cause ovarian pathology?
Cysts
Endometriosis
Tumours
Where can ovarian cysts arise from?
They can arise from any element of the ovary. Follicular- e.g. polycystic ovaries
Luteal
Endometriotic
Epithelial
Mesothelial- these are uncommon.
Describe a follicular cyst?
The follicle doesn’t rupture and grows until it forms a cyst. They are thin walled and lined by granulosa cells.
At what point in the cycle do follicular cysts occur at?
They occur when ovulation doesn’t happen e.g. the follicle doesn’t rupture and the oocyte isn’t released.
Are follicular cysts common?
Yes.
Do follicular cysts grow? if so to what size? Do they need treatment?
They can grow to several cms in size. If they grow, that may be a worrying sign. They usually resolve themselves within a few months.
What is endometriosis?
Endometrial glands and ströma outwit the uterine cavity.
What symptoms/signs can endometriosis cause?
May cause infertility, pelvic inflammation and pain.
If endometriosis occurs in the ovary, what is it known as?
Chocolate cysts.
What other sites can endometriosis commonly affect?
Pouch of Douglas
Peritoneal surfaces- including uterus (not inside on the outside)
Cervix, vulva, vagina
Bladder, bowel.
What is endometriosis in the myometrium known as?
Adenomyosis.
Describe the pathogenesis of endometriosis?
Three steps- Regurgitation: glands in the stroma shed in the endometrial cavity each month. These somehow manage to get up the Fallopian tubes and into other body cavities
Metaplasia-transition from one epithelial cell type to another
Then vascular or lymphatic dissemination.
Macroscopically, how does endometriosis look?
Peritoneal spots or nodules
Fibrous adhesions
Chocolate cysts.
Microscopically, how does endometriosis look?
Endometrial glands and stroma.
Haemorrhage, inflammation and fibrosis.
What complications can occur with endometriosis?
Pain
Cyst formation
Adhesions- inflammation can cause adhesions with the bowel etc.
Infertility- if it involves the Fallopian tube or ovary
Ectopic pregnancy
Malignancy
Which cancers is endometriosis a precursor for?
Endometroid adenocarcinoma or clear cell carcinoma.
Where can ovarian tumours arise from? (tissues)
Epithelial Germ cell
Sex cord/stromal
Metastatic
Miscellaneous
What makes up epithelial ovarian tumours?
As the ovary doesn’t have epithelium, its always from somewhere else. These include:
- Serous
- Mucinous- mesothelium over the surface of the ovary. When the follicle ruptures it can become embedded in the stroma and become metaplastic. -Endometroid- get there by endometriosis
- Clear cell- get there by endometriosis
- Brenner -Undifferentiated carcinoma. These are all thought to be tubal in origin- e.g. something in the tubes falling onto the ovary.
Epithelial ovarian tumours are classified as benign, borderline or malignant. Describe each.
Benign- No cytological abnormalities. Proliferative activities absent or scant. No stromal invasion
Borderline-Cytological abnormalities. Proliferative. No stroll invasion Malignant- cytological abnormalities.
Proliferative. Stromal invasion.
How can serous carcinoma be classified?
As high grade serous carcinoma or low grade serous carcinoma.
Describe high grade serous carcinoma?
Serous tubal intraepithelial carcinoma (STIC)
Most are tubal in origin.
Describe low grade serous carcinomas?
Serous borderline tumour.
This pic tells you where the stroma is.

This is a high grade serous carcinoma.